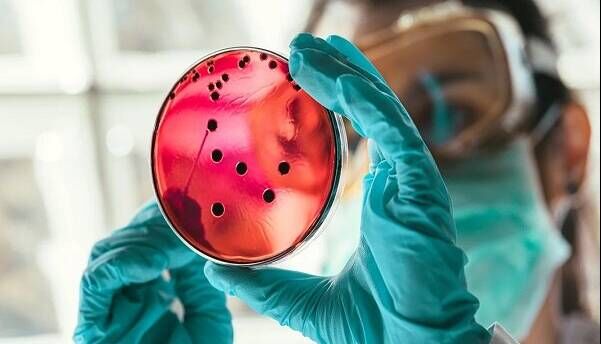
درمان اختلالات خونی با نانوذرات لیپیدی درمان اختلالات خونی با نانوذرات لیپیدی

به گزارش گروه وبگردی حیات؛ این یافتهها در قالب مقالهای در نشریه Science منتشر شد. این روش تحویل میتواند هزینهها را کاهش داده و دسترسی به ژن درمانی را افزایش دهد.
این مدل توسط محققان دانشکده پزشکی پرلمن در دانشگاه پنسیلوانیا ایجاد شده است. با ارائه ابزارهای ویرایش ژن از این طریق، سلولهای خونی بیمار میتوانند مستقیماً در بدن اصلاح شوند.
ایده پشت ویرایش ژن داخل بدن، از بین بردن نیاز به رژیمهای درمانی سخت مانند پرتودرمانی یا شیمی درمانی است که در حال حاضر برای درمان بیماران مبتلا به بیماریهایی مانند بیماری سلول داسی و تالاسمی بتا برای پیوند سلول خونساز یا ژن درمانی استفاده میشود.
حمیده پرهیز از محققان این پروژه میگوید: «در این پروژه، ما نانوذرات لیپیدی را مورد استفاده قرار میدهیم تا mRNA درمانی/ویراستاران ژن را بهعنوان یک فناوری پلتفرم در داخل بدن حمل کند و در نهایت از آن برای برنامهریزی مجدد سلول در داخل بدن استفاده کرده و برای بسیاری از بیماریها که نیاز به درمانی ژن دارند، به شکل هدفمند استفاده شود. ما در این پروژه آخرین دستاوردهای درمانی mRNA و ابزارهای ویرایش ژن مبتنی بر RNA را ترکیب کردیم تا روش جدیدی برای کنترل سرنوشت سلولهای بنیادی خونساز و اصلاح نقص ژنتیکی فراهم کنیم.»
لورا بردا از محققان این پروژه در بیمارستان کودکان فیلادلفیا گفت: «این یافتهها ممکن است ژن درمانی را تغییر دهد این کار نه تنها با اجازه اصلاح ژنی خاص در سلول با کمترین خطر انجام میشود بلکه پلتفرمی را عرضه میکند که در صورت تنظیم مجدد امکان استفاده برای بسیاری از اختلالات را خواهد داشت. این روش جدید میتواند دستکاریهایی را که قبلاً غیرممکن بود، امکانپذیر کند. چنین سیستمهای تحویل جدید ممکن است به پیادهسازی وعدههایی که دهها سال قبل داده شده بود، جامعه عمل بپوشاند.»

نظر شما